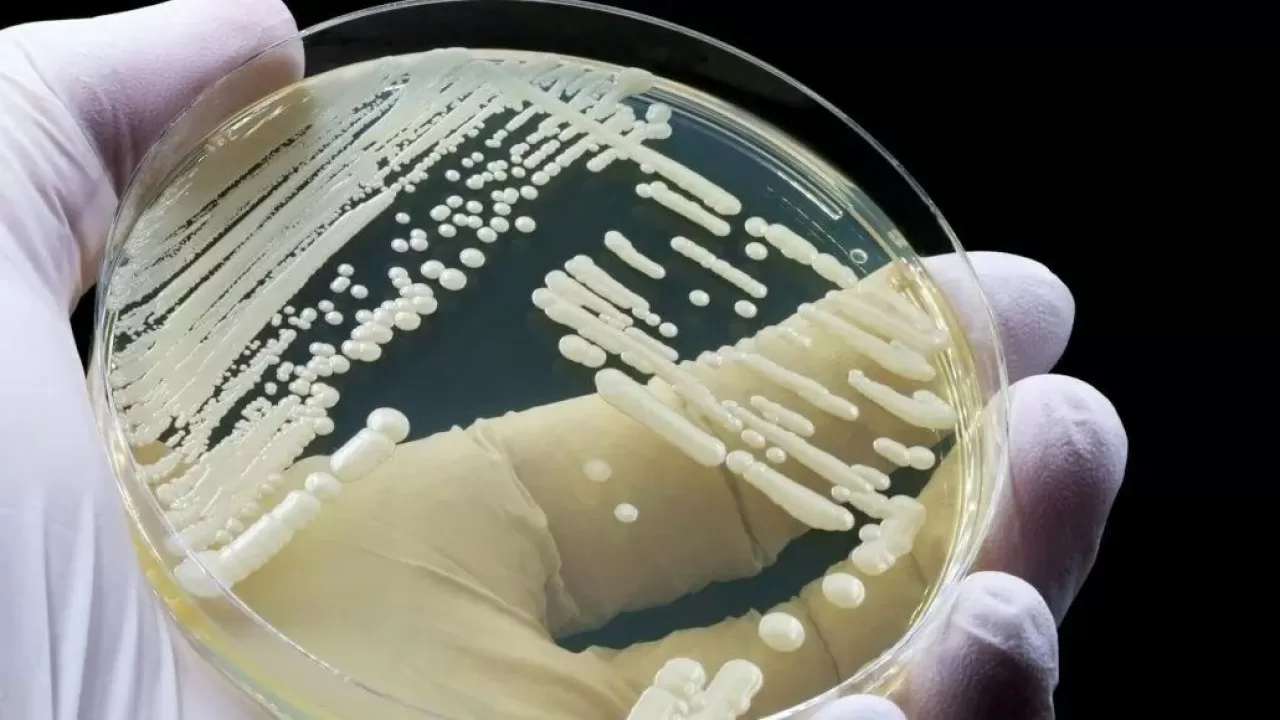
Өте жұқпалы вирус әлемге қауіп-қатер тудырып тұр

Оны емдеу оңай емес әрі вирус өте жылдам таралады, деп хабарлайды inbusiness.kz сайты Doctorpiter басылымына сілтеме жасап.
Candida auris – ашытқы тектес саңырауқұлақ штаммы. Ол терідегі жеңіл инфекциялардан бастап, өмірге қауіпті ауруларға, қанның жұқпалы зақымдануына дейін әкелуі мүмкін.
Аталған саңырауқұлақ вирусы тұңғыш рет 2009 жылы Жапониядан табылған еді. Кейіннен Үндістанға да таралып, онда аса қауіпті инфекция ретінде бағаланды. Қазіргі уақытта Candida auris 6 құрлыққа қауіп-қатерін төндіруде.
Ғалымдар жаһандық жылыну мен жоғары ылғал Candida auris-тің көбеюіне қолайлы жағдай жасап отырғанын алға тартады. Мұнан өзге саңырауқұлақтың теріге жабысып қалуына көмектесетін арнайы ақуыздары және дәрілік заттарды ағзадан шығарып жіберетін "сорғы" секілді тетіктері тағы бар.
– Саңырауқұлақтар вирустар мен паразиттермен салыстырғанда жеткілікті деңгейде зерттелмеген. Десе де, бұл деректер болашақта саңырауқұлақ тектес патогендер әлемнің көптеген аймағына әсер етуі мүмкін екенін көрсетеді, – дейді профессор Норман ван Рейн.
Осыған байланысты ғалымдар қазіргі уақытта жаңа әрі тиімді зеңге қарсы дәрілерді әзірлеу аса маңызды екенін қатаң ескертіп отыр.